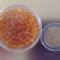

Il sito di baratto online asincrono per lo scambio, il riuso e il riutilizzo di oggetti usati, nonché banca del tempo.
 Perline arancio
Perline arancio
0
Perline colore arancio
Nuove
Rho (MI)
Perline arancio
scambiatoCategoria: Abbigliamento / Accessori
12/03/20
L'annuncio è stato scambiato con cinzias lunedì 30 marzo 2020
30/03/2020 00:17:50 Diafra2000 - Rho (MI)
Diafra2000 - Rho (MI)
Diafra2000 ha modificato i crediti dell'annuncio: da 1 li ha portati a 0.
 Diafra2000 - Rho (MI)
Diafra2000 - Rho (MI)
Diafra2000 ha modificato i crediti dell'annuncio: da 1 li ha portati a 0.
30/03/2020 00:17:28 Diafra2000 - Rho (MI)
Diafra2000 - Rho (MI)
Si si clicca pure. Te le metto a zero che ha chiesto tante cose
Ciao
 Diafra2000 - Rho (MI)
Diafra2000 - Rho (MI)
Si si clicca pure. Te le metto a zero che ha chiesto tante cose
Ciao
12/03/2020 17:39:46 Celeste - Varese (VA)
Celeste - Varese (VA)
Ma la Madonna aveva chiesto la consacrazione della Russia e non è stata mai fatta...
 Celeste - Varese (VA)
Celeste - Varese (VA)
Ma la Madonna aveva chiesto la consacrazione della Russia e non è stata mai fatta...
12/03/2020 16:55:40 Diafra2000 - Rho (MI)
Diafra2000 - Rho (MI)
Comunque l affidamento dell umanità a Maria non è una cosa da poco... :-(
 Diafra2000 - Rho (MI)
Diafra2000 - Rho (MI)
Comunque l affidamento dell umanità a Maria non è una cosa da poco... :-(
12/03/2020 16:54:43 Diafra2000 - Rho (MI)
Diafra2000 - Rho (MI)
Si ti giro il link del messaggio del Papa per l affidamento alla Madonna. Ma comunque lo avranno fatto anche su radiomaria. Ip guardo tv2000 che è "parente" di radiomaria (credo)
 Diafra2000 - Rho (MI)
Diafra2000 - Rho (MI)
Si ti giro il link del messaggio del Papa per l affidamento alla Madonna. Ma comunque lo avranno fatto anche su radiomaria. Ip guardo tv2000 che è "parente" di radiomaria (credo)
12/03/2020 16:32:12 Celeste - Varese (VA)
Celeste - Varese (VA)
Ciao, dici in TV?
Io non ho il televisore, seguo le S. Messe su radiomissionefrancescana oppure su facebook nella pagina di Don Leonardo Maria Pompei, quest'ultimo l'affidamento alla Madonna lo fa quasi tutti i giorni.
Ti scrivo in pvt l'indirizzo?
 Celeste - Varese (VA)
Celeste - Varese (VA)
Ciao, dici in TV?
Io non ho il televisore, seguo le S. Messe su radiomissionefrancescana oppure su facebook nella pagina di Don Leonardo Maria Pompei, quest'ultimo l'affidamento alla Madonna lo fa quasi tutti i giorni.
Ti scrivo in pvt l'indirizzo?
12/03/2020 15:47:36 Diafra2000 - Rho (MI)
Diafra2000 - Rho (MI)
Secondo me si. Sono leggere.
È un disastro purtroppo. Ieri sera hai sentito la messa con la ffidamento alla Madonna?
Volevo mandarti un messaggio ma ora che lo avresti letto era finito
Ciao
 Diafra2000 - Rho (MI)
Diafra2000 - Rho (MI)
Secondo me si. Sono leggere.
È un disastro purtroppo. Ieri sera hai sentito la messa con la ffidamento alla Madonna?
Volevo mandarti un messaggio ma ora che lo avresti letto era finito
Ciao
12/03/2020 15:32:26 Celeste - Varese (VA)
Celeste - Varese (VA)
Che dici levando la scatolina e mettendole in una bustina, potrebbero viaggiare con posta4?
 Celeste - Varese (VA)
Celeste - Varese (VA)
Che dici levando la scatolina e mettendole in una bustina, potrebbero viaggiare con posta4?
12/03/2020 15:30:46 Celeste - Varese (VA)
Celeste - Varese (VA)
Ciao, sono indecisa, mi servirebbero, ma forse mi arrivano prima se le compro in Cina (sono seria)
 Celeste - Varese (VA)
Celeste - Varese (VA)
Ciao, sono indecisa, mi servirebbero, ma forse mi arrivano prima se le compro in Cina (sono seria)